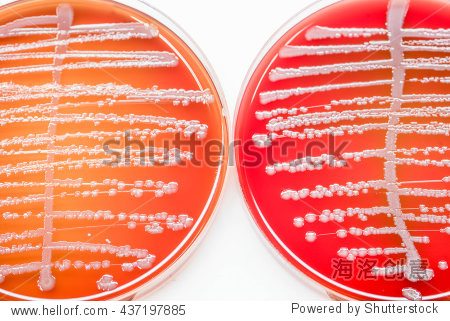
staphylococcus aureus/ staphylococcus spp. bacterial culture gro

Staphylococcus

staphylococcus图片大全_staphylococcus高清图片素材 - canva可画
图片尺寸550x413
staphylococcus aureus
图片尺寸460x224
实践中的新方法:临床试验.
图片尺寸648x694
【预售】staphylococcus: molecular genetics
图片尺寸542x800
医生发现一种可怕的新耐药性"超级细菌" - cnbeta.com 移动版
图片尺寸745x776
金黄色葡萄球菌检验(staphylococcus).ppt
图片尺寸800x600
colony of staphylococcus aureus bacteria causing skin infection
图片尺寸450x358
海外直订staphylococcus: genetics and physiology 葡萄球菌:遗传学
图片尺寸800x800
superbug bacteria or staphylococcus aureus (mrsa) bacteria
图片尺寸1200x840
莉莎·毕法露 - wikivisually
图片尺寸480x373
staphylococcus aureus | food poisoning lawyers
图片尺寸670x503
预订staphylococcus aureus toxins
图片尺寸278x400
科学家发现葡萄球菌疫苗在人类身上不起作用的原因 - it 与健康 - cnb
图片尺寸700x465
预订staphylococcus aureus
图片尺寸800x800
staphyloccocus aureus rosenbach
图片尺寸661x349
金黄色葡萄球菌,就在你我身边 - 食品微生物检测 - 食品论坛 - powere
图片尺寸255x336
difference between micrococcus and staphylococcus - pediaa.com
图片尺寸714x544
superbug or staphylococcus aureus (mrsa) bacteria
图片尺寸1200x857
successful in vivo test of breakthrough staphylococcus aureus va
图片尺寸500x384
staphylococcus aureus/ staphylococcus spp. bacterial culture gro
图片尺寸450x321